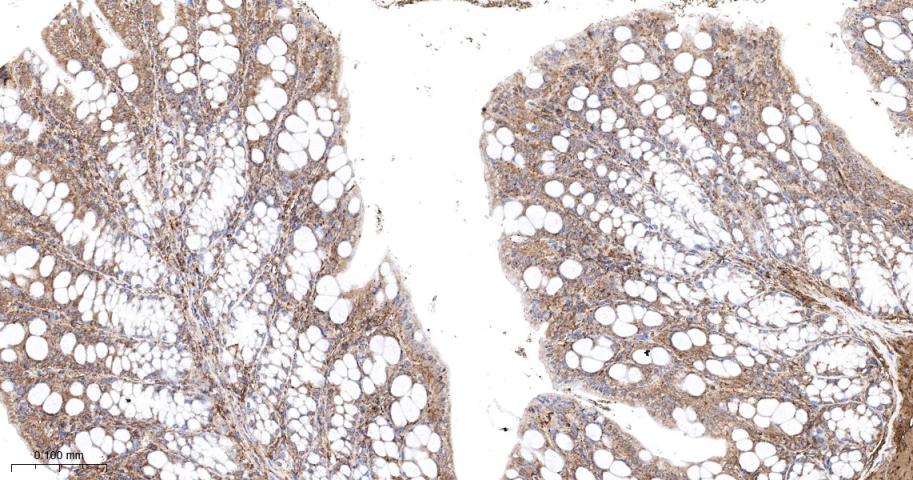
原癌基因Ras重组兔单抗

原癌基因Ras重组兔单抗
Rrmab?兔单抗

货号:bsm-62921R
产品详情
相关标记
相关产品
相关文献
常见问题
概述
产品编号
bsm-62921R
产品类型
重组兔单抗
英文名称
Ras Recombinant Rabbit mAb
中文名称
原癌基因Ras重组兔单抗
英文别名
ALPS4; CMNS; KRAS; N-ras; NCMS; NRAS1; NS6; RASN_HUMAN; NRAS; Transforming protein N-Ras; 3.6.5.2; HRAS1;
抗体来源
Rabbit
免疫原
A synthesized peptide derived from human Ras: 25-50
亚型
IgG
性状
Liquid
纯化方法
affinity purified by Protein A
克隆类型
Recombinant
克隆号
8H2
理论分子量
21,22 kDa
检测分子量
22 kDa
储存液
10mM phosphate buffered saline(pH 7.4) with 150mM sodium chloride, 0.05% BSA, 0.02% Proclin300 and 50% glycerol.
研究领域
SWISS
Gene ID
保存条件
Store at 4℃ for short term. Store at -20℃ for long term. Avoid repeated freeze/thaw cycles.
注意事项
This product as supplied is intended for research use only, not for use in human, therapeutic or diagnostic applications.
产品介绍
细胞信号转导系统紊乱是肿瘤细胞生长的重要特征之一,Ras蛋白参与体内多种细胞信号转导途径而发挥作用,而原癌基因N-ras是一种多功能的细胞因子,广泛存在于自然界,N-ras在多种细胞生命活动中起极为重要的作用,包括细胞的增殖、分化和细胞骨架的构建等等,该抗体主要用于肿瘤方面的研究。
背景资料
Ras proteins bind GDP/GTP and possess intrinsic GTPase activity.

产品应用
| 应用 | 已检合格种属 | 预测种属 | 推荐稀释比例 |
|---|---|---|---|
| WB | Human, Mouse, Rat | 1:500-2000 | |
| IHC-P | Human, Mouse, Rat | 1:100-500 | |
| IHC-F | Human, Mouse, Rat | 1:100-500 | |
| IF | Human, Mouse, Rat | 1:100-500 | |
| Flow-Cyt | Human, Mouse, Rat | 1:50-100 | |
| ICC/IF | Human, Mouse, Rat | 1:50-200 | |
| IP | Human, Mouse, Rat | 1:20-50 |
交叉反应
交叉反应: Human, Mouse, Rat
相关产品
暂无相关产品
靶标
基因名
NRAS
蛋白名
GTPase NRas
亚基
Interacts (active GTP-bound form preferentially) with RGS14. Interacts (active GTP-bound form) with RASSF7.
亚细胞定位
Cell membrane; Lipid-anchor; Cytoplasmic side. Golgi apparatus membrane; Lipid-anchor. Note=Shuttles between the plasma membrane and the Golgi apparatus.
组织特异性
Widely expressed.
翻译后修饰
Palmitoylated by the ZDHHC9-GOLGA7 complex. A continuous cycle of de- and re-palmitoylation regulates rapid exchange between plasma membrane and Golgi.
Acetylation at Lys-104 prevents interaction with guanine nucleotide exchange factors (GEFs).
Acetylation at Lys-104 prevents interaction with guanine nucleotide exchange factors (GEFs).
疾病
Leukemia, juvenile myelomonocytic (JMML) [MIM:607785]: An aggressive pediatric myelodysplastic syndrome/myeloproliferative disorder characterized by malignant transformation in the hematopoietic stem cell compartment with proliferation of differentiated progeny. Patients have splenomegaly, enlarged lymph nodes, rashes, and hemorrhages. Note=The disease is caused by mutations affecting the gene represented in this entry.
Noonan syndrome 6 (NS6) [MIM:613224]: A form of Noonan syndrome, a disease characterized by short stature, facial dysmorphic features such as hypertelorism, a downward eyeslant and low-set posteriorly rotated ears, and a high incidence of congenital heart defects and hypertrophic cardiomyopathy. Other features can include a short neck with webbing or redundancy of skin, deafness, motor delay, variable intellectual deficits, multiple skeletal defects, cryptorchidism, and bleeding diathesis. Individuals with Noonan syndrome are at risk of juvenile myelomonocytic leukemia, a myeloproliferative disorder characterized by excessive production of myelomonocytic cells. Note=The disease is caused by mutations affecting the gene represented in this entry.
Autoimmune lymphoproliferative syndrome 4 (ALPS4) [MIM:614470]: A disorder of apoptosis, characterized by chronic accumulation of non-malignant lymphocytes, defective lymphocyte apoptosis, and an increased risk for the development of hematologic malignancies. Note=The disease is caused by mutations affecting the gene represented in this entry.
Noonan syndrome 6 (NS6) [MIM:613224]: A form of Noonan syndrome, a disease characterized by short stature, facial dysmorphic features such as hypertelorism, a downward eyeslant and low-set posteriorly rotated ears, and a high incidence of congenital heart defects and hypertrophic cardiomyopathy. Other features can include a short neck with webbing or redundancy of skin, deafness, motor delay, variable intellectual deficits, multiple skeletal defects, cryptorchidism, and bleeding diathesis. Individuals with Noonan syndrome are at risk of juvenile myelomonocytic leukemia, a myeloproliferative disorder characterized by excessive production of myelomonocytic cells. Note=The disease is caused by mutations affecting the gene represented in this entry.
Autoimmune lymphoproliferative syndrome 4 (ALPS4) [MIM:614470]: A disorder of apoptosis, characterized by chronic accumulation of non-malignant lymphocytes, defective lymphocyte apoptosis, and an increased risk for the development of hematologic malignancies. Note=The disease is caused by mutations affecting the gene represented in this entry.
相似性
Belongs to the small GTPase superfamily. Ras family.
功能
Ras proteins bind GDP/GTP and possess intrinsic GTPase activity.
标记抗体
暂无标记数据
同靶标产品
暂无同靶标产品
相关文献
提示: 发表研究结果有使用 bsm-62921R 时请让我们知道,以便我们可以引用参考文章。作为回馈,资料提供者将获得我们送上的小礼品。
暂无相关文献
常见问题
暂无常见问题